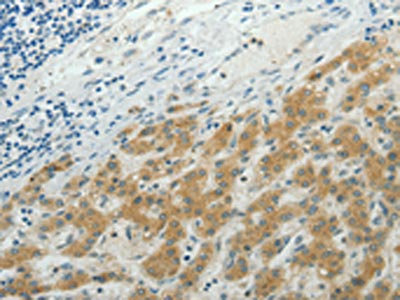

NDRG2 Antibody
-
中文名稱:NDRG2兔多克隆抗體
-
貨號(hào):CSB-PA071884
-
規(guī)格:¥1100
-
圖片:
-
The image on the left is immunohistochemistry of paraffin-embedded Human liver cancer tissue using CSB-PA071884(NDRG2 Antibody) at dilution 1/50, on the right is treated with synthetic peptide. (Original magnification: ×200)
-
The image on the left is immunohistochemistry of paraffin-embedded Human lung cancer tissue using CSB-PA071884(NDRG2 Antibody) at dilution 1/50, on the right is treated with synthetic peptide. (Original magnification: ×200)
-
Gel: 10%SDS-PAGE, Lysate: 40 μg, Lane: Human brain malignant glioma tissue, Primary antibody: CSB-PA071884(NDRG2 Antibody) at dilution 1/950, Secondary antibody: Goat anti rabbit IgG at 1/8000 dilution, Exposure time: 1 minute
-
-
其他:
產(chǎn)品詳情
-
Uniprot No.:
-
基因名:NDRG2
-
別名:Antidepressant related protein ADRG123 antibody; Cytoplasmic protein Ndr1 antibody; DKFZp781G1938 antibody; FLJ25522 antibody; KIAA1248 antibody; N myc downstream regulated gene 2 antibody; N myc downstream regulator 2 antibody; NDR1 related protein NDR2 antibody; NDRG 2 antibody; NDRG family member 2 antibody; NDRG1 related protein antibody; NDRG2 antibody; NDRG2_HUMAN antibody; Protein NDRG2 antibody; Protein Syld709613 antibody; SYLD antibody; Syld709613 protein antibody
-
宿主:Rabbit
-
反應(yīng)種屬:Human,Mouse,Rat
-
免疫原:Synthetic peptide of Human NDRG2
-
免疫原種屬:Homo sapiens (Human)
-
標(biāo)記方式:Non-conjugated
-
抗體亞型:IgG
-
純化方式:Antigen affinity purification
-
濃度:It differs from different batches. Please contact us to confirm it.
-
保存緩沖液:-20°C, pH7.4 PBS, 0.05% NaN3, 40% Glycerol
-
產(chǎn)品提供形式:Liquid
-
應(yīng)用范圍:ELISA,WB,IHC
-
推薦稀釋比:
Application Recommended Dilution ELISA 1:1000-1:5000 WB 1:500-1:2000 IHC 1:25-1:100 -
Protocols:
-
儲(chǔ)存條件:Upon receipt, store at -20°C or -80°C. Avoid repeated freeze.
-
貨期:Basically, we can dispatch the products out in 1-3 working days after receiving your orders. Delivery time maybe differs from different purchasing way or location, please kindly consult your local distributors for specific delivery time.
-
用途:For Research Use Only. Not for use in diagnostic or therapeutic procedures.
相關(guān)產(chǎn)品
靶點(diǎn)詳情
-
功能:Contributes to the regulation of the Wnt signaling pathway. Down-regulates CTNNB1-mediated transcriptional activation of target genes, such as CCND1, and may thereby act as tumor suppressor. May be involved in dendritic cell and neuron differentiation.
-
基因功能參考文獻(xiàn):
- NDRG2 knockdown promotes renal fibrosis through its effect on the protein and mRNA expression of epithelial-mesenchymal transition markers. PMID: 28646304
- Data show that Sentrin/SUMO specific protease (SENP2) interacts with N-myc downstream regulated gene 2 (NDRG2) and mediates the de-SUMOylation process of NDRG2. PMID: 29060933
- Down-regulation of NDRG2 promotes cancer cell proliferation and neoplasm invasion through regulation by microRNA-454. PMID: 29080452
- Increased level of NDRG2 in cortex or hippocampus may be a potential risk for Alzheimer's disease. NDRG2 increased Abeta1-42 might be related to the changes of BEAC1 and GGA3. It might also affect CDK5 and tau overphosphorylation. NDRG2 interacting with STAT3 and modulating Fas/Fasl signaling pathway plays important roles in cell death. PMID: 28670853
- Lower expression of KLF4 and NDRG2 in colorectal cancer patients was correlated with poor overall survival. Thus, KLF4 inhibited the proliferation of colorectal cancer cells dependent on NDRG2 signaling, which provides a novel strategy for therapy and early diagnosis of colorectal cancer. PMID: 28656310
- NDRG2 could be a potential independent diagnostic biomarker for bladder cancer. PMID: 28953854
- The different NDRG2 promoter methylation and expression levels in pituitary adenoma samples showed tumor heterogeneity and indicates a potential role of this gene in pituitary adenoma pathogenesis. PMID: 28390436
- NDRG2 expression decreased in adriamycin resistance breast cancer cells. NDRG2 can promote adriamycin sensitivity by inhibiting proliferation, enhancing cellular damage responses, and promoting apoptosis in a p53-dependent manner. PMID: 28423695
- Authors investigate the clinical and pathological role of NDRG2 in human malignant tumors. The absence of NDRG2 expression is associated with oncogenic properties through the loss of its role as a tumor suppressor; NDRG2 overexpression inhibits proliferation, adhesion, and invasion, whereas its expression is low or undetectable in various cancers. [Review] PMID: 27113371
- These findings indicate that SUMOylation of NDRG2 is necessary for its tumor suppressor function in lung adenocarcinoma and that RNF4 increases the efficiency of this process. PMID: 27072586
- NDRG2 is a novel ERS-responsive protein and acts as PERK co-factor to facilitate PERK branch, thereby contributing to ERS-induced apoptosis. PMID: 28948615
- Our results show how NDRG2 expression serves as a critical determinant of the invasive and metastatic capacity of oral squamous cell carcinoma (OSCC) PMID: 28209617
- putative tumor suppressive function of NDRG2 may be confined to luminal- and basal B-type breast cancers PMID: 27400234
- Overexpression of NDRG2 can inhibit the proliferation. PMID: 28031114
- present results suggest that hypermethylation in promoter around exon 2 is functioning as essential factors of NDRG2 silencing in gastrointestinal cancers PMID: 28093228
- NDRG2 overexpression significantly reduced hepatoma cell proliferation and enhanced cell apoptosis under glucose limitation. Moreover, NDRG2 overexpression aggravated energy imbalance and oxidative stress by decreasing the intracellular ATP and NADPH generation and increasing ROS levels. PMID: 28069379
- The methylation status of the NDRG2 promoter in PBMCs is a potential noninvasive biomarker to predict the severity of liver fibrosis. PMID: 28202850
- Data show that downregulation of NDRG2 may play an important role in advanced hepatoblastomas. PMID: 26646663
- Study shows that NDRG2 was significantly down-regulated in glioblastomas (GBM) and seems to play a role in GBM prognosis. The low expression of NDRG2 at the mRNA level leads to a longer progression-free survival independent of methylation status. PMID: 26976975
- Stuidies indicate the potential of N-myc downstream-regulated gene 2 (NDRG2) as a therapeutic target for cancer. PMID: 26506239
- NDRG2 overexpression enhanced sodium/iodide symporter level in thyroid tumor cells and increased their iodine uptake in vitro. PMID: 26802650
- Epigenetic silencing of NDRG2 promotes colorectal cancer proliferation and invasion. PMID: 26250123
- miR-301a/b-NDRG2 might be an important axis modulating autophagy and viability of prostate cancer cells under hypoxia. PMID: 26813459
- Loss of NDRG2 induced the expression of matrix metalloproteinase-19 (MMP-19), which regulated the expression of Slug at the transcriptional level in the epithelial-mesenchymal transition of gallbladder carcinoma cells. PMID: 26292259
- The forced expression of NDRG2 in ATL cells down-regulates not only the canonical pathway by inhibiting AKT signaling but also the non-canonical pathway by inducing NF-kappaB-inducing kinase (NIK) dephosphorylation via the recruitment of PP2A PMID: 26269411
- NDRG2 functions as an essential regulator in glycolysis and glutaminolysis via repression of c-Myc, and acts as a suppressor of carcinogenesis. PMID: 26317652
- This review summarizes the distribution and subcellular localization of NDRG2 in brain tissues, highlights the physiological actions of NDRG2 in the nervous system, and discusses the roles of NDRG2 during the occurrence of nervous system disease. [review] PMID: 26341979
- NDRG2 suppresses the proliferation of human bladder cancer cells via induction of oncosis. PMID: 26239274
- Authors found that H. pylori silenced Ndrg2 by activating the NF-kappaB pathway and up-regulating DNMT3b, promoting gastric cancer progression. Findings uncover a previously unrecognized role for H. pylori infection in gastric cancer. PMID: 25823664
- NDRG2 acts as a negative regulator downstream of androgen receptor and inhibits the growth of androgen-dependent and castration-resistant prostate cancer. PMID: 25756511
- The downregulation of NDRG2 combined with the upregulation of CD24 may play a synergistic role in the occurrence and progression of hepatocellular carcinoma. PMID: 25338637
- NDRG2 was negatively correlated with Bcl-2 in gastric cancer tissues. PMID: 25854572
- NDRG2 can significantly inhibit the proliferation of OS-RC-2 cells in vitro and its protein is specifically expressed in the mitochondrion PMID: 24839115
- these data show that the inhibition of NF-kappaB signaling by NDRG2 expression is able to suppress cell migration and invasion through the down-regulation of COX-2 expression. PMID: 25256221
- NDRG2/gp130/STAT3 pathway can mediate the antimetastatic effects of Dp44mT in hepatocellular carcinoma. PMID: 25261367
- findings show NDRG2 expression is downregulated in glioma and level of NDRG2 expression negatively correlates with glioma grade;findings also indicate NDRG2 downregulation may be due to aberrant methylation of NDRG2 promoter region and subsequent transcriptional inactivation PMID: 24840052
- Data suggest targeting the actions of N-myc downstream-regulated gene 2 (NDRG2) in cell glucose-dependent energy delivery may provide a strategy for therapeutic intervention in breast carcinoma. PMID: 24636131
- Data show the expression of N-myc downstream-regulated gene 2 (NDRG2) is frequently downregulated in adult T-cell leukaemia-lymphoma, resulting in enhanced phosphorylation of PTEN and activation of the phosphatidylinositol 3-kinase (PI3K)-AKT pathway. PMID: 24569712
- the inhibition of STAT3 signaling by NDRG2 suppresses EMT progression of EMT via the down-regulation of Snail expression PMID: 25153349
- Taken together, these data indicate that NDRG2 inhibits the proliferation of neuroblastoma cells partially through suppression of cysteine-rich protein 61. PMID: 24528032
- NDRG2 overexpression can inhibit tumor growth and invasion in vitro. PMID: 24146910
- NDRG2 expression with cell density preceded E-cadherin expression, and the regulation of Snail activity by GSK-3beta was also related to this process. PMID: 23900729
- the expression of NDRG2 is an independent prognostic factor in pancreatic cancer. PMID: 24134849
- The present experiments demonstrated that NDRG2 may be a diagnostic and prognostic marker in patients with oesophageal squamous cell carcinoma PMID: 23800335
- NDRG2 gene expression can be induced by hyperthermia and is correlated with neoplasm invasion in hepatocellular carcinoma. PMID: 23630579
- findings bring insight to the roles of NDRG2 in ischemic-hypoxic injury and provide potential targets for future clinical therapies on stroke PMID: 23451161
- NDRG2 gene expression is down-regulated in atypical and recurrent meningiomas. PMID: 20607352
- These data showed that NDRG2 may play an important role in human lung cancer tumourigenesis PMID: 23307246
- Our results suggest that the decreased expression of NDRG2 or the increased expression of CD24 is an important feature of lung adenocarcinoma. PMID: 22528516
- NDRG2 could suppress clear cell renal cell carcinoma cell invasion through regulating MMP-9 expression and activity. PMID: 22692967
顯示更多
收起更多
-
亞細(xì)胞定位:Cytoplasm. Cytoplasm, perinuclear region. Cell projection, growth cone.
-
蛋白家族:NDRG family
-
組織特異性:Highly expressed in brain, heart, skeletal muscle and salivary gland, and moderately in kidney and liver. Expressed in dendritic cells, but not in other blood cells. Expression levels are low in pancreatic and liver cancer tissues; absent in meningioma. E
-
數(shù)據(jù)庫鏈接:
Most popular with customers
-
-
YWHAB Recombinant Monoclonal Antibody
Applications: ELISA, WB, IHC, IF, FC
Species Reactivity: Human, Mouse, Rat
-
Phospho-YAP1 (S127) Recombinant Monoclonal Antibody
Applications: ELISA, WB, IHC
Species Reactivity: Human
-
-
-
-
-